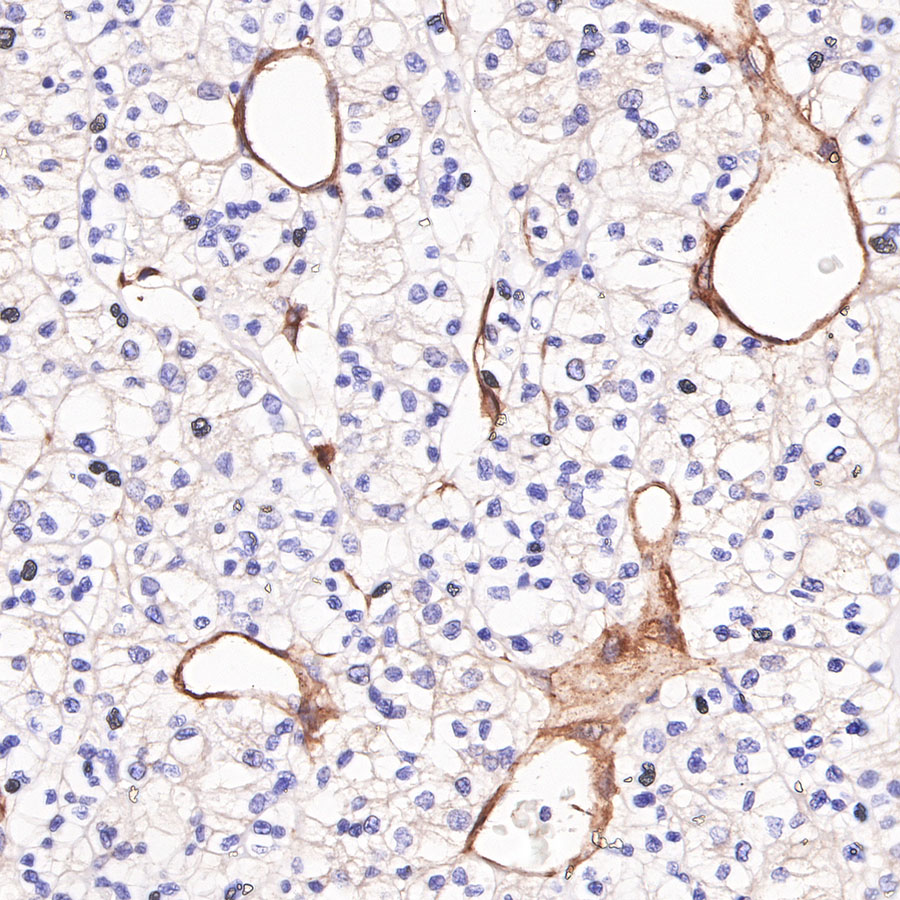
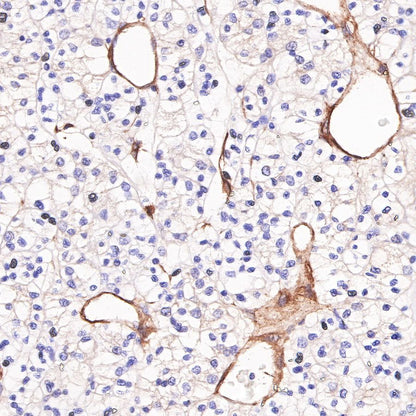

Product Specification
| Host |
Rabbit |
| Antigen |
CD146 |
| Synonyms |
MEL-CAM, MUC18, P1H12, A32 |
| Immunogen |
Synthetic Peptide |
| Location |
Membrane |
| Accession |
P43121 |
| Clone Number |
SDT-348-6 |
| Antibody Type |
Recombinant mAb |
| Application |
WB, IHC-P, IP |
| Reactivity |
Hu, Ms, Rt |
| Predicted Reactivity |
Hm |
| Purification |
Protein A |
| Concentration |
0.5 mg/ml |
| Tag |
N/A |
| Physical Appearance |
Liquid |
| Storage Buffer |
PBS, 40% Glycerol, 0.05% BSA, 0.03% Proclin 300 |
| Stability & Storage |
12 months from date of receipt / reconstitution, -20 °C as supplied |
Dilution
| application |
dilution |
species |
| WB |
1:1000 |
|
| IHC-P |
1:1000-1:2000 |
|
| IP |
1:50 |
|
Background
Cluster of differentiation 146 (CD146) is a cell adhesion molecule (CAM) which belongs to the immunoglobulin superfamily (IgSF) [PMID: 3542195]. Human CD146 has previously been designated several synonyms, including MUC18 [PMID: 3542195, PMID: 2602381], A32 antigen [PMID: 8162602,PMID: 7943174], S-Endo-1 [PMID: 8573133], melanoma CAM (MCAM or Mel-CAM) [PMID: 7943174, PMID: 8616875, PMID: 9187135], metastasis CAM (MET-CAM) and hemopoietic CAM (HEMCAM). The avian homolog of CD146 has been named gicerin [PMID: 8161457]. CD146 was originally identified as a marker for melanoma (MCAM), due to its overexpression in metastatic lesions and advanced primary tumors, yet not in benign lesions. Increasing amounts of evidence have demonstrated that CD146 is overexpressed in a variety of carcinomas, in addition to melanomas [PMID: 16804906, PMID: 22826148, PMID: 22754372, PMID: 22210108]. As a result of this characteristic, CD146 has attracted attention and is considered to be a potential marker for tumor diagnosis, prognosis and treatment. The majority of studies support the theory that CD146 promotes tumor growth, angiogenesis and metastasis [PMID: 19356677], therefore, CD146 is a promising target for tumor therapy [PMID: 17121934, PMID: 22977083].